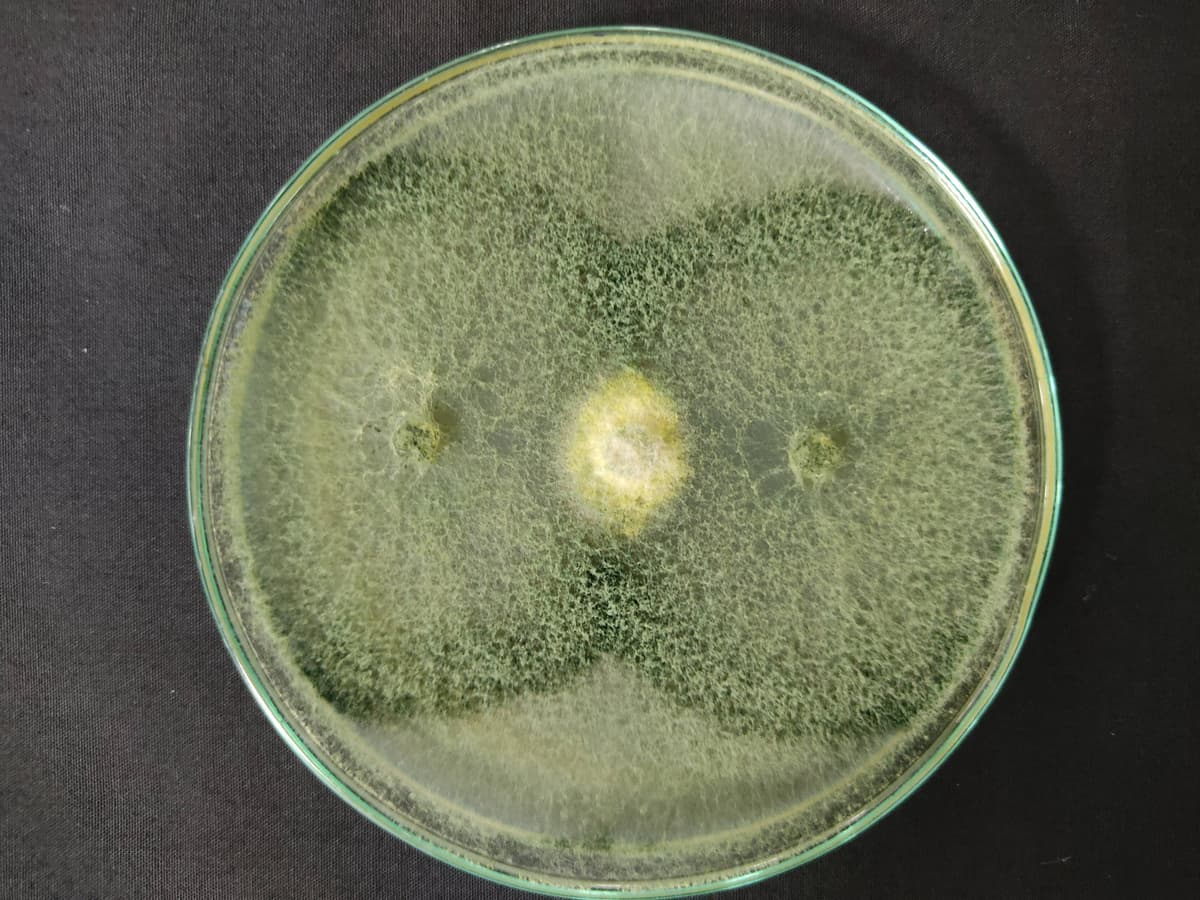
Inititiative image

The fungus Fusarium oxysporum f. sp. cubense is one of the most devastating pathogens for global production of Musaceae that includes bananas, plantains and abaca. Its incidence in crops threatens one of the main exports and a fundamental pillar of the economy of countries such as Ecuador, Costa Rica, Colombia, Nicaragua, Peru, Mexico, Guatemala, among others. In addition, it puts the food security and income diversification of vulnerable populations such as plantain and abaca producers at risk.
The recent report on tropical Foc Race 4 in LAC demands the joint work of the actors in the value chain.
Work is being done on the standardization of Foc TR4 diagnostic protocols for INIAs and project partners, based on new methodologies that allow detection in complex samples: water and soil. Progress is being made in the validation of technologies for disease prevention and management through the evaluation of disinfectants, development of unified and validated biosafety protocols for small banana and plantain producers, and the evaluation of biological products (Trichoderma spp. and Bacillus subtillis). In addition, as a medium-term strategy, progress has been made in the successful development of protocols for the safe introduction of Musa spp germplasm to Colombia that will serve as a model for other countries. Through this protocol, banana materials from CIRAD (France) and Embrapa (Brazil) have been introduced due to their resistance to Foc TR4. The set of technological solutions will make it possible to manage the disease in LAC in a more sustainable, resilient and intelligent way.
Protocols for the detection of Foc TR4 were standardized in the INIAs attached to the project, controls were delivered for the validation of their internal protocols and personnel were trained in the methodologies. The biosafety baseline was determined in the 6 countries and progress is being made in the construction of a biosafety model for small producers. In Colombia, promising results were found in biological products for pathogen control based on Trichoderma spp. and B. subtilis. Four genotypes with promising characteristics due to their resistance to Foc TR4 from the CIRAD breeding program were introduced to Colombia: Ruby, CIRAD 924, 931, 938 and 52 banana genotypes from Embrapa, including improved diploids and tetraploids, for integration into the Musaceae breeding program. Susceptibility of Colombian Creole plantains was found under greenhouse conditions and with high concentration of inoculum.